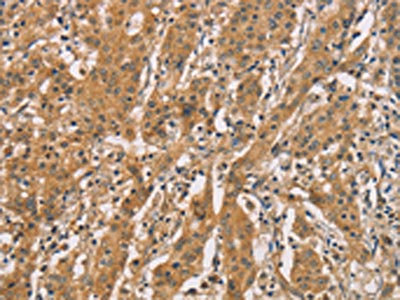

CDCP1 Antibody
-
中文名稱:CDCP1兔多克隆抗體
-
貨號:CSB-PA952668
-
規格:¥1100
-
圖片:
-
The image on the left is immunohistochemistry of paraffin-embedded Human gastic cancer tissue using CSB-PA952668(CDCP1 Antibody) at dilution 1/50, on the right is treated with synthetic peptide. (Original magnification: ×200)
-
The image on the left is immunohistochemistry of paraffin-embedded Human thyroid cancer tissue using CSB-PA952668(CDCP1 Antibody) at dilution 1/50, on the right is treated with synthetic peptide. (Original magnification: ×200)
-
Gel: 6%SDS-PAGE, Lysate: 80 μg, Lane 1-2: A549 cells, hepG2 cells, Primary antibody: CSB-PA952668(CDCP1 Antibody) at dilution 1/800, Secondary antibody: Goat anti rabbit IgG at 1/8000 dilution, Exposure time: 10 seconds
-
-
其他:
產品詳情
-
Uniprot No.:
-
基因名:
-
別名:9030022E12Rik antibody; AA409659 antibody; CD 318 antibody; CD_antigen=CD318 antibody; CD318 antibody; CD318 antigen antibody; CDCP 1 antibody; Cdcp1 antibody; CDCP1_HUMAN antibody; CUB domain containing protein 1 antibody; CUB domain-containing protein 1 antibody; E030027H19Rik antibody; FLJ13772 antibody; FLJ22375 antibody; FLJ22969 antibody; Membrane glycoprotein gp140 antibody; MGC31813 antibody; OTTHUMP00000164120 antibody; OTTHUMP00000209568 antibody; RGD1305578 antibody; SIMA 135 antibody; SIMA135 antibody; Subtractive immunization M plus HEp3 associated 135 kDa protein antibody; Subtractive immunization M plus HEp3-associated 135 kDa protein antibody; Transmembrane and associated with src kinases antibody; TRASK antibody
-
宿主:Rabbit
-
反應種屬:Human
-
免疫原:Synthetic peptide of Human CDCP1
-
免疫原種屬:Homo sapiens (Human)
-
標記方式:Non-conjugated
-
抗體亞型:IgG
-
純化方式:Antigen affinity purification
-
濃度:It differs from different batches. Please contact us to confirm it.
-
保存緩沖液:-20°C, pH7.4 PBS, 0.05% NaN3, 40% Glycerol
-
產品提供形式:Liquid
-
應用范圍:ELISA,WB,IHC
-
推薦稀釋比:
Application Recommended Dilution ELISA 1:1000-1:5000 WB 1:500-1:2000 IHC 1:50-1:200 -
Protocols:
-
儲存條件:Upon receipt, store at -20°C or -80°C. Avoid repeated freeze.
-
貨期:Basically, we can dispatch the products out in 1-3 working days after receiving your orders. Delivery time maybe differs from different purchasing way or location, please kindly consult your local distributors for specific delivery time.
-
用途:For Research Use Only. Not for use in diagnostic or therapeutic procedures.
相關產品
靶點詳情
-
功能:May be involved in cell adhesion and cell matrix association. May play a role in the regulation of anchorage versus migration or proliferation versus differentiation via its phosphorylation. May be a novel marker for leukemia diagnosis and for immature hematopoietic stem cell subsets. Belongs to the tetraspanin web involved in tumor progression and metastasis.
-
基因功能參考文獻:
- Expression of CDCP1 was reduced by AHCC treatment of KLM1-R cells, whereas expression of actin was not affected. The ratio of intensities of CDCP1/actin in AHCC-treated KLM1-R cells was significantly suppressed (p<0.05) compared to untreated cells. PMID: 30396925
- Co-expression of CDCP1 and AXL is often observed in EGFR-mutation-positive tumors, limiting the efficacy of EGFR TKIs. Co-treatment with EGFR TKI and TPX-0005 warrants testing. PMID: 29433983
- CDCP1 knockdown reduced 3D invasion, which can be rescued by ACSL3 co-knockdown. In vivo, inhibiting CDCP1 activity with an engineered blocking fragment (extracellular portion of cleaved CDCP1) lead to increased LD abundance in primary tumors, decreased metastasis, and increased ACSL activity in two animal models of TNBC. PMID: 28739932
- These results revealed that ADAM9 down-regulates miR-1 via activating EGFR signaling pathways, which in turn enhances CDCP1 expression to promote lung cancer progression. PMID: 28537886
- CDCP1 is a novel marker of the most aggressive N-positive triple-negative breast cancers; CDCP1 expression and gains in CDCP1 copy number synergized with nodal (N) status in determining disease-free and distant disease-free survival PMID: 27626701
- High expression level of CDCP1 is associated with recurrence in glioblastoma. PMID: 26956052
- These studies have important implications for the development of a therapeutic to block CDCP1 activity and Triple-negative breast cancer (TNBC)metastasis. PMID: 26876198
- CDCP1 may facilitate loss of adhesion by promoting activation of EGFR and Src at sites of cell-cell and cell-substratum contact. PMID: 27495374
- Stromal expression patterns for both ADAM12 and CDCP1. PMID: 27685922
- these data demonstrated that HIF-2alpha could promote hepatocellular carcinoma cell migration by regulating CDCP1 PMID: 26307391
- Our results establish that differential glycosylation, cell surface presentation and extracellular expression of CDCP1 are hallmarks of prostate cancer progression. PMID: 26497208
- High CDCP1 expression is associated with Colorectal Cancer. PMID: 25820997
- ADAM9 enhances CDCP1 protein expression by suppressing miR-218 for lung tumor metastasis PMID: 26553452
- Elevated CDCP1 was observed in 77% of HGSC cases. Silencing of CDCP1 reduced migration and non-adherent cell growth in vitro and tumour burden in vivo. PMID: 26882065
- CDCP1 protein plays an important role in the progression of ovarian clear cell carcinoma. Elevated CDCP1 levels correlates with poor patient outcome in ovarian clear cell carcinoma patients. PMID: 25893298
- CDCP1 overexpression enhances HER2 activity. CDCP1 binds to HER2, promoting SRC-HER2 crosstalk. PMID: 25892239
- Multiple tyrosine phosphorylation sites of CDCP1 are important for the functional regulation of SFKs in several tumor types. PMID: 25728678
- These data suggest CDCP1 expression can be used to identify a subset of marrow fibroblasts functionally distinct from CD146+ fibroblasts. PMID: 25275584
- The aim of this study was to examine whether activation of Trask may be potentially important in brain metastasis of lung cancers, the commonest site of organ spread and producing the deadliest consequences. PMID: 25775948
- decreased CDCP1 expression promoted the invasive and migratory abilities of esophageal cancer cell lines. PMID: 24849519
- CDCP1 protein induced by oncogenic Ras/Erk signaling is essential for Ras-mediated metastatic potential of cancer cells. PMID: 24939643
- CDCP1 modulates cell-substratum adhesion and motility in colon cancer cell lines. PMID: 25301083
- EGF increases the lifespan of CDCP1 promoting its availability on the cell surface where the data indicate it is available to mediate procancer phenotypes such as cell migration. PMID: 24681947
- CDCP1 is an essential regulator of the trafficking and function of MT1-MMP- and invadopodia-mediated invasion of cancer cells. PMID: 23439492
- CDCP1 represses the epithelial phenotype of pancreatic cancer cells. PMID: 24384474
- Complexing of beta1 integrin the 70-kDa with CDCP1 fragment induced intracellular phosphorylation signaling, involving focal adhesion kinase-1 (FAK) and PI3 kinase (PI3K)-dependent Akt activation PMID: 23208492
- Expression and phosphorylation of exogenous CDCP1 by Fyn kinase reduced the formation of autophagosomes. PMID: 23510015
- In migrating cancer stem cells isolated from primary human colorectal cancers, CD110(+) and CDCP1(+) subpopulations mediate organ-specific lung and liver metastasis. PMID: 23747337
- strongly expressed in tumors derived from lung, colon, ovary, or kidney. for a full transformation capacity, the intact amino- and carboxy-termini of CDCP1 are essential. PMID: 23300860
- These data support a critical role for CDCP1 as a unique HIF-2alpha target gene involved in the regulation of cancer metastasis. PMID: 23378636
- Secreted CDCP1 can be a useful genetic marker for the diagnosis of metastatic prostate cancer. PMID: 22457534
- a novel role for CDCP1 in EGF/EGFR-induced cell migration and indicate that targeting of CDCP1 may be a rational approach to inhibit progression of cancers driven by EGFR signaling PMID: 22315226
- Data show that the signaling events that accompany the CDCP1 tyrosine phosphorylation observed in cell lines and lung tumors may explain how the CDCP1/SFK complex regulates motility and adhesion. PMID: 21725358
- Trask as one of several potential candidates for functionally relevant tumor suppressors on the 3p21.3 region of the genome frequently lost in human cancers. PMID: 21706059
- analysis of cellular settings mediating Src Substrate switching between focal adhesion kinase tyrosine 861 and CUB-domain-containing protein 1 (CDCP1) tyrosine 734 PMID: 21994943
- CDCP1 is selectively expressed in ovarian tumor vasculature PMID: 21617380
- CUB domain-containing protein 1 (CDCP1) is a substrate of Src family kinases and has been shown to regulate anoikis resistance, migration and matrix degradation during tumor invasion and metastasis in a tyrosine phosphorylation-dependent manner. Review. PMID: 21812858
- analysis of structural features of Trask that mediate its anti-adhesive functions PMID: 21559459
- Src-Trask signaling and Src-focal adhesion signaling inactivate each other, constituting two opposing modes of phosphotyrosine signaling that define a switch underlining cell anchorage state. PMID: 21490433
- Data provide molecular mechanisms for the metastasis-enhancing functions of CDCP1. PMID: 21220330
- Signal transduction from CDCP1 to PKCdelta leads to its activation, increasing migration of CC-RCC. Furthermore, patient survival can be stratified by CDCP1 expression at the cell surface of the tumor PMID: 21233420
- Trask signaling and focal adhesion signaling inactivate each other and signal in exclusion with each other, constituting a switch that underlies cell anchorage state. PMID: 21189288
- biological role of this protein and, potentially, its function in cancer, may be mediated by both 70-kDa cell retained and 65-kDa shed fragments, as well as the full-length 135-kDa protein. PMID: 20551327
- Overexpression of CDCP1 is associated with pancreatic cancers. PMID: 20501830
- In endometrioid adenocarcinoma low CDCP1 and advanced stage were independent poor prognostic factors for both overall and disease-free survival. PMID: 20372833
- findings indicate a functional role for CDCP1 in cancer and underscore the therapeutic potential of function-blocking anti-CDCP1 antibodies targeting both primary and metastatic carcinoma cells PMID: 19916495
- antibodies generated by subtractive immunization used to purify, identify and partially characterize SIMA135/CDCP1; properties indicate it is a multidomain cell surface antigen, highly expressed by certain cancer cells and normal and cancerous colon PMID: 12660814
- tyrosine phosphorylation of CDCP1 is regulated by adhesion or plasmin in epithelial cells PMID: 14739293
- CDCP1 is not only a novel marker for immature hematopoietic progenitor cell subsets but also unique in its property to recognize cells with phenotypes reminiscent of MSC and NPC. PMID: 15153610
- When CDCP1 promoter was transfected exogenously, Jurkat showed comparable promoter activity with K562, suggesting that the factor to enhance transcription was present but interfered to function in Jurkat PMID: 16926850
顯示更多
收起更多
-
亞細胞定位:[Isoform 1]: Cell membrane; Single-pass membrane protein. Note=Shedding may also lead to a soluble peptide.; [Isoform 3]: Secreted.
-
組織特異性:Highly expressed in mitotic cells with low expression during interphase. Detected at highest levels in skeletal muscle and colon with lower levels in kidney, small intestine, placenta and lung. Up-regulated in a number of human tumor cell lines, as well a
-
數據庫鏈接:
Most popular with customers
-
-
YWHAB Recombinant Monoclonal Antibody
Applications: ELISA, WB, IHC, IF, FC
Species Reactivity: Human, Mouse, Rat
-
-
-
-
-
-